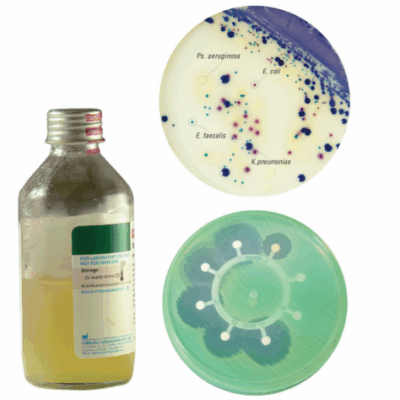

Microbiologie
Showing 13–24 of 38 results
-
Coloranți și indicatori
-
6-Place Dispenser
-
Discuri pentru diferențierea microorganismelor
-
Seturi pentru diagnostic urogenital
-
Seturi pentru testarea sterilității
-
Seturi pentru preluarea mostrelor de pe suprafețe HiTouch™
-
Slanturi în flacoane de sticlă
-
Medii dehidratate sub formă de praf
-
Medii dehidratate în granule
-
Medii dehidratate în capsule
-
Medii lichide în tuburi
-
Flacoane de sticlă cu medii lichide